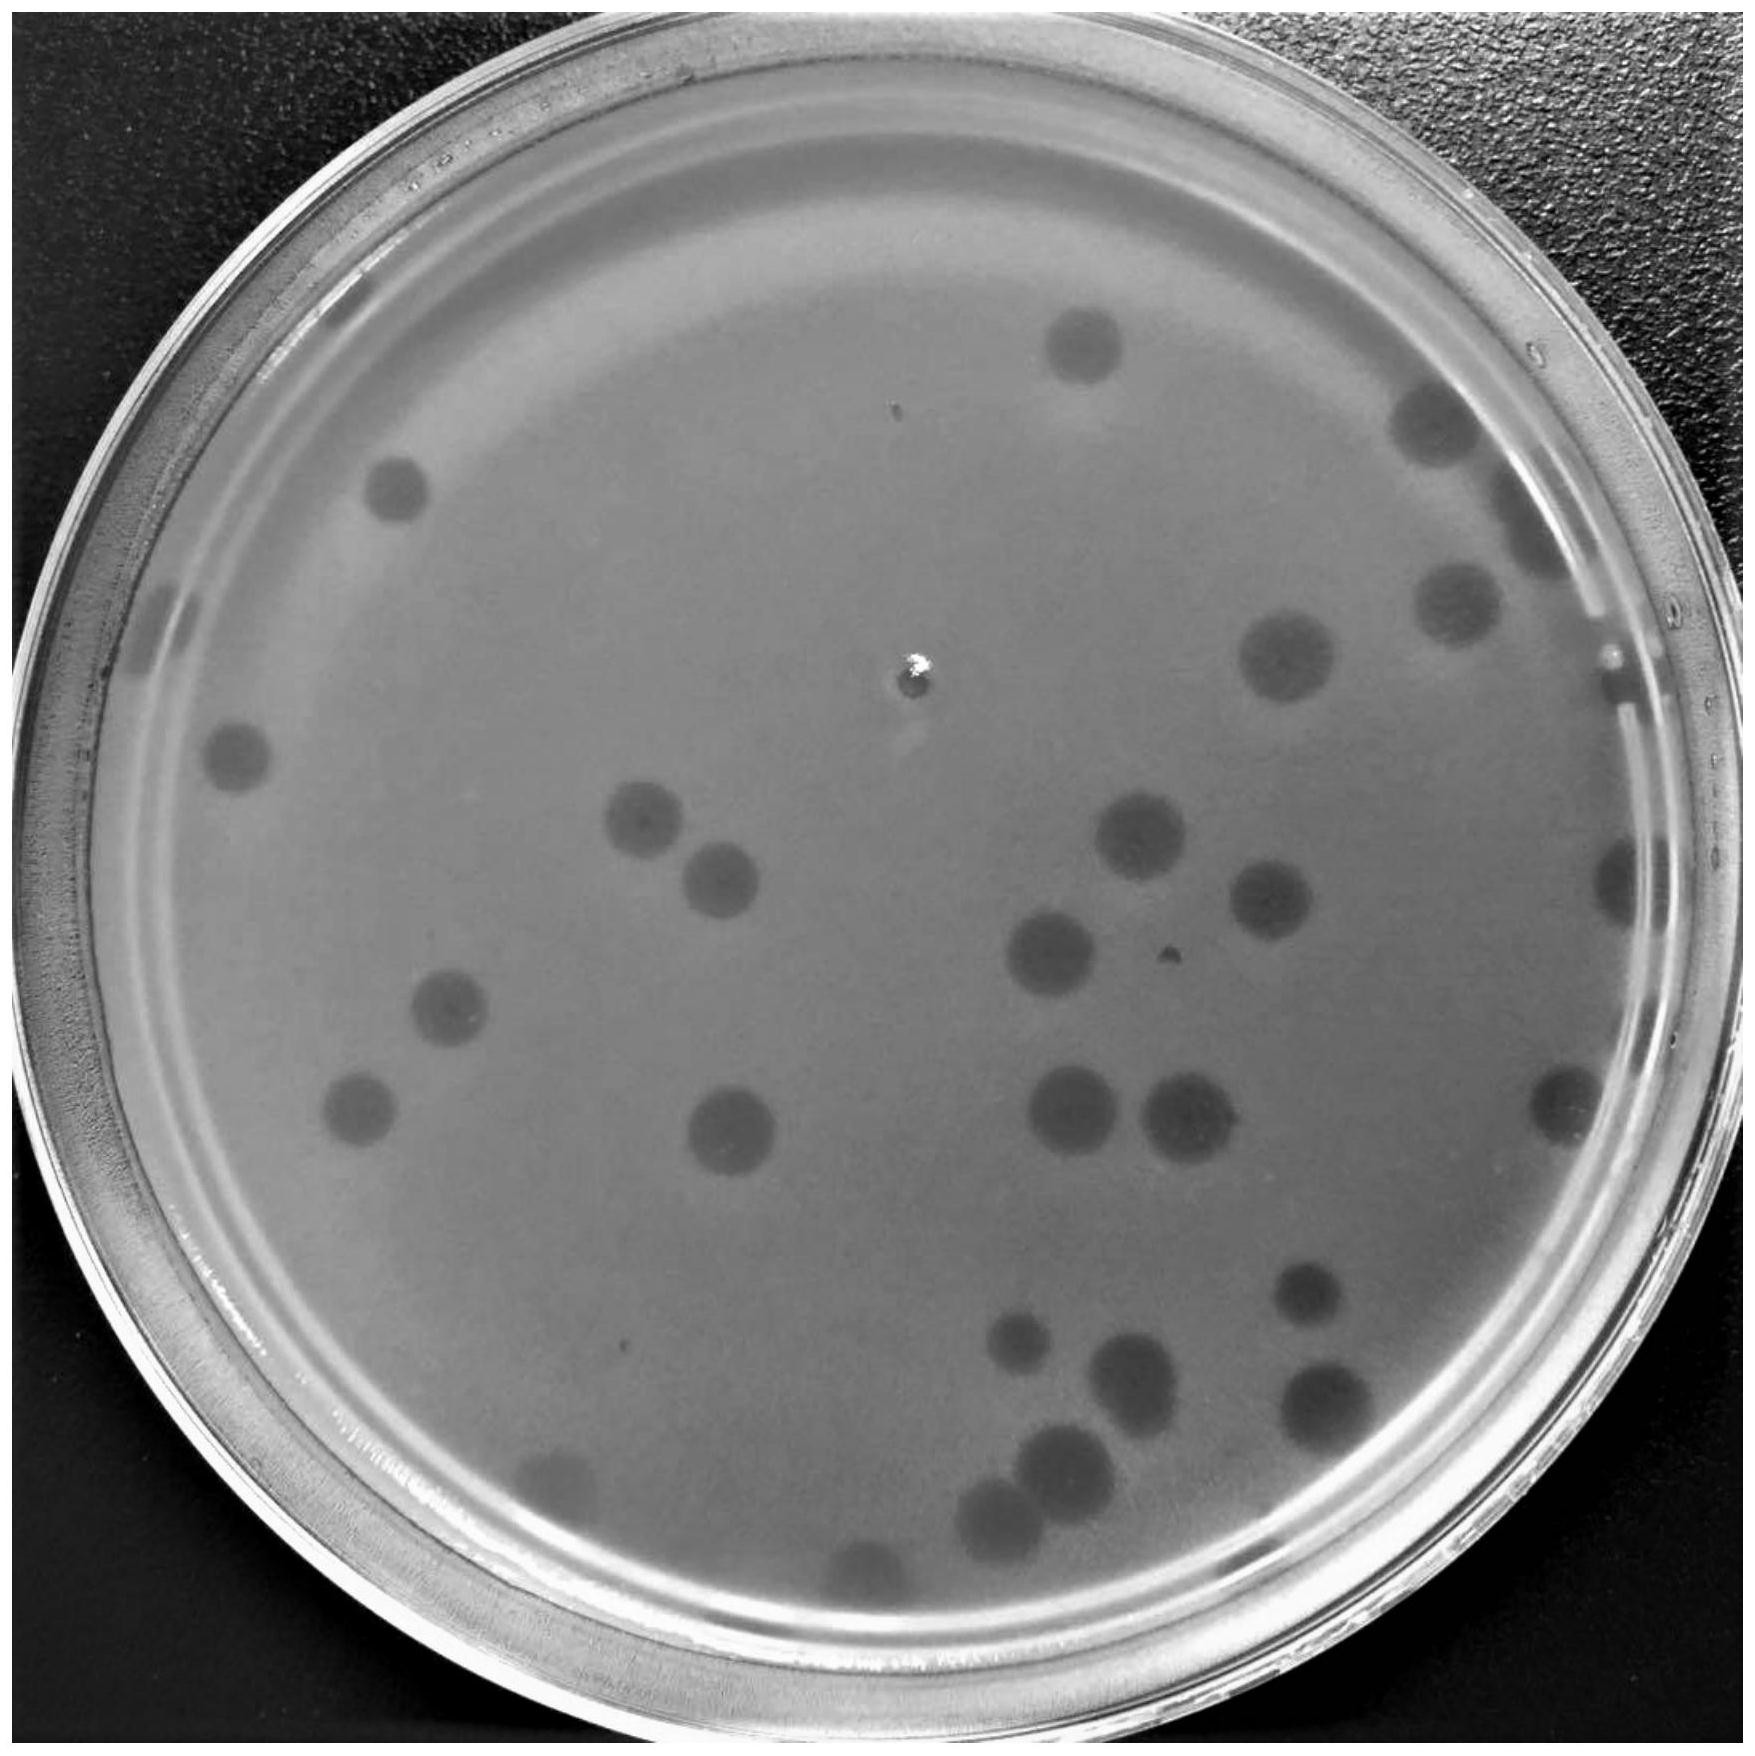
一种地毯草黄单胞菌噬菌体及其组合物试剂盒和应用
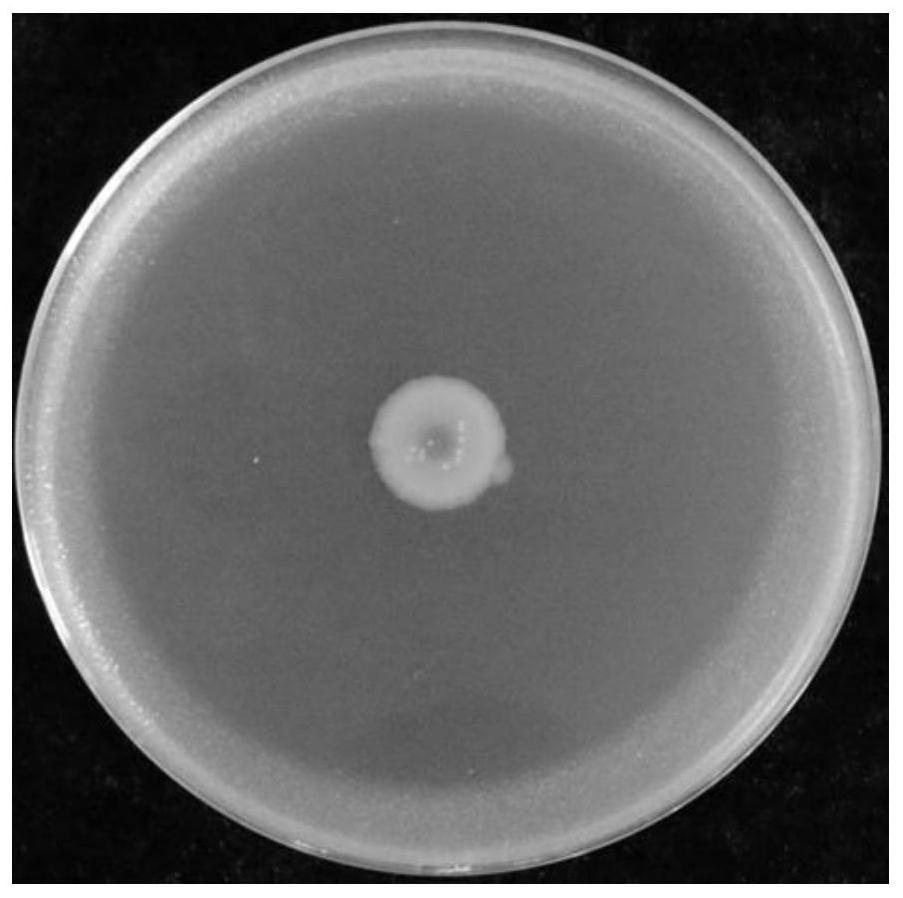
cn112359000a_一株高效生防假单胞菌及其在水稻病害防治中的应用

黄单胞杆菌

一种拮抗水稻黄单胞菌的溶杆菌及其分离方法与应用与流程
图片尺寸800x813
树生黄单胞菌(现2)
图片尺寸320x280![地毯草黄单胞菌发酵生产黄原胶工艺条件优化[j].](https://i.ecywang.com/upload/1/img2.baidu.com/it/u=648825510,2711531799&fm=253&fmt=auto&app=138&f=JPEG?w=642&h=500)
地毯草黄单胞菌发酵生产黄原胶工艺条件优化[j].
图片尺寸700x545
想问下平板中那几个呈黄色的菌落是什么菌 - 食品微生物检测 - 食品
图片尺寸800x1068
扫描电镜下的金黄色葡萄球菌菌落该院每年平均能接到五六例被人咬伤
图片尺寸1080x838
柱状黄杆菌镜检图(40*10)
图片尺寸817x614
黄色短杆菌
图片尺寸300x240
变黄假单胞菌
图片尺寸400x422
伯顿毕赤酵母
图片尺寸400x300
天格尔黄杆菌
图片尺寸640x435
微生物降解塑料取得黄!10小时可分解90%,细菌将拯救地球?
图片尺寸1524x1508
请问这黄色的菌类植物是什么?
图片尺寸800x1066
nbrc3521=atcc13985 绿针假单胞菌 价格
图片尺寸220x198
「并不是所有慢阻肺的病人都容易感染铜绿假单胞菌,易感染的主要是
图片尺寸673x444
金黄色葡萄球菌镜下及培养基(版权归嵩神所有)
图片尺寸600x800
一种地毯草黄单胞菌噬菌体及其组合物试剂盒和应用
图片尺寸1755x1756
natrevmicrobiol黄单胞菌种群多样性和毒力因子以及植物病原菌互作
图片尺寸1080x775
专《茶树病虫害防治》实验课件ppt 棉角斑单胞杆菌细菌,黄单胞杆菌属
图片尺寸1080x810
cn112359000a_一株高效生防假单胞菌及其在水稻病害防治中的应用
图片尺寸903x898
巴氏黄单胞菌
图片尺寸268x165


![地毯草黄单胞菌发酵生产黄原胶工艺条件优化[j].](https://i.ecywang.com/upload/1/img2.baidu.com/it/u=648825510,2711531799&fm=253&fmt=auto&app=138&f=JPEG?w=642&h=500)

















![地毯草黄单胞菌发酵生产黄原胶工艺条件优化[j].](https://www.fjnyxb.cn/fileFJNYXB/journal/article/fjnyxb/2017/7/PIC/fjnyxb-32-7-762-8.jpg)